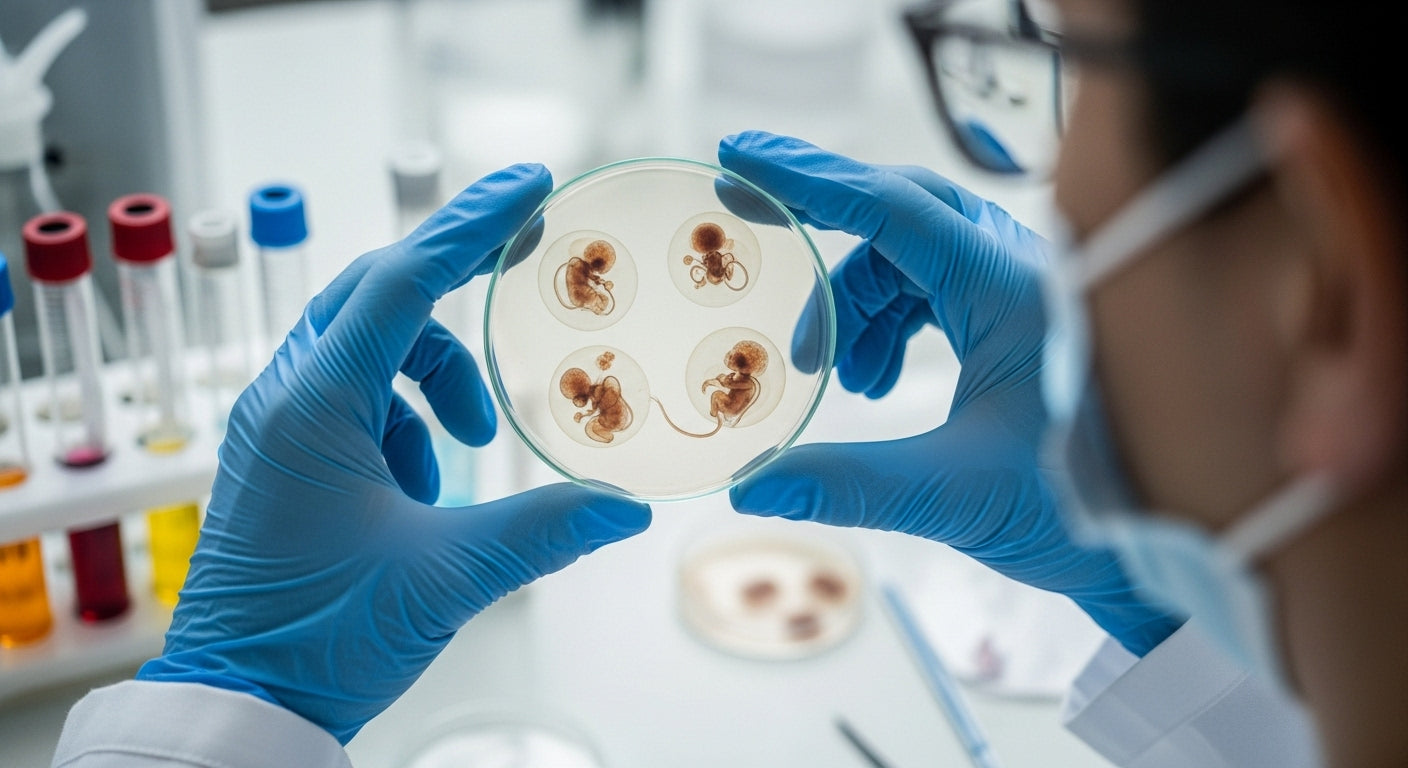
IVF baby

Guides
- All
- baby development
- baby milestones
- baby sign language
- Baby Strollers
- baby-care
- child development
- child-development
- children
- compact stroller
- early development
- education
- elementary
- family
- fertility
- foldable stroller
- friendship
- heredity
- infant communication
- IVF
- maternal-health
- parenting
- parenting tips
- pregnancy
- pregnancy-health
- pregnancy-nutrition
- preschool
- reproductive health
- social skills
- speech development
- Strollers
- timeline
- toddler
- toddler communication
- Travel Stroller
How Long Does IVF Take? Complete Timeline Guide for Your Fertility Journey
Are you wondering how long your IVF journey will take? You're not alone in asking this crucial question. Every year, over 300,000 IVF cycles are performed in the United States, with couples spending months preparing for and undergoing treatment. The...